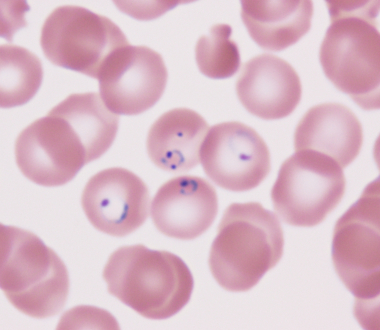
Ring form malaria parasites in red blood cells on a Giemsa-stained blood slide

A manuscript coauthored by scientists from the New York State Department of Health’s Wadsworth Center and Bureau of Communicable Disease Control, in collaboration with the U.S. Centers for Disease Control and Prevention (CDC) and epidemiologists from the New York City Department of Health and Mental Hygiene and Westchester County Department of Health, has now been published in Open Forum Infectious Diseases and selected as the journal’s Editor’s Choice article.
The paper describes the investigation of a patient diagnosed with malaria in fall 2023 despite no history of international travel. Using targeted next-generation sequencing at the Wadsworth Center and whole-genome sequencing at the CDC, investigators demonstrated that the parasites were a genetic match to those from a concurrently hospitalized traveler, providing strong evidence of healthcare-associated transmission.
This work highlights the critical role of advanced genomic technologies and bioinformatics at the Wadsworth Center in solving complex public health investigations and underscores the value of continued investment in cutting-edge molecular diagnostics to protect patients and communities.